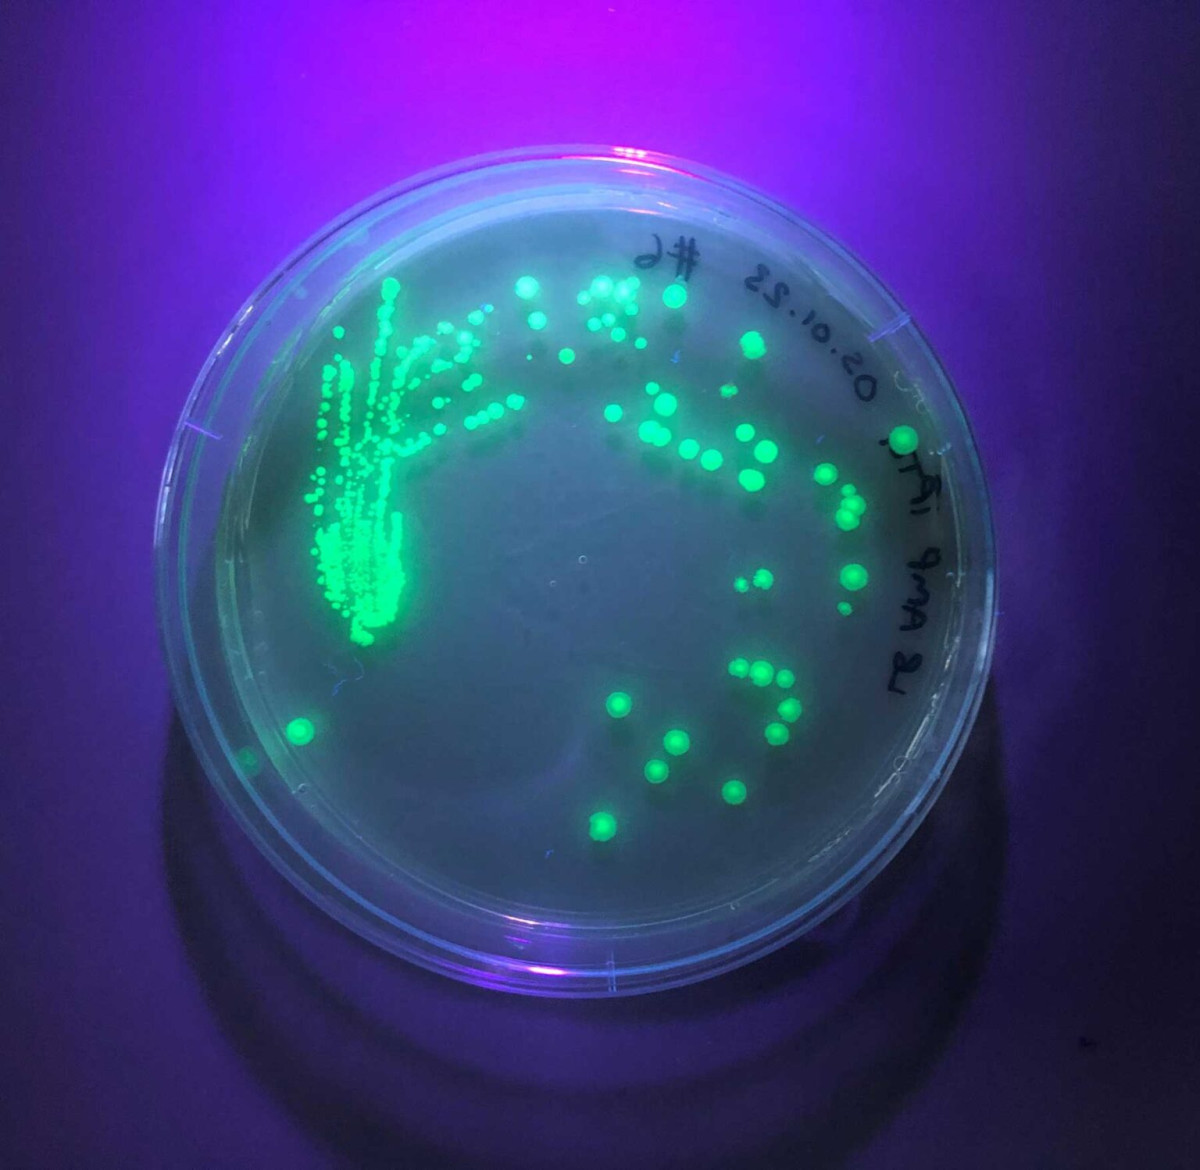

The GENE project is generously supported by the PTFA, which provides annual funding to ensure the continuation of this valuable extracurricular programme. Their support enables students to gain hands-on experience with advanced molecular biology techniques, preparing them for further studies and careers in biosciences.